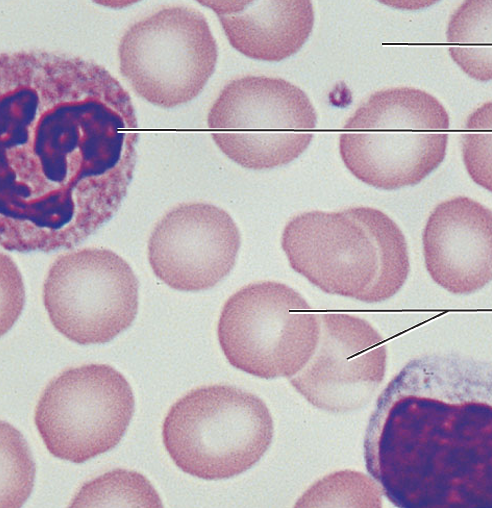
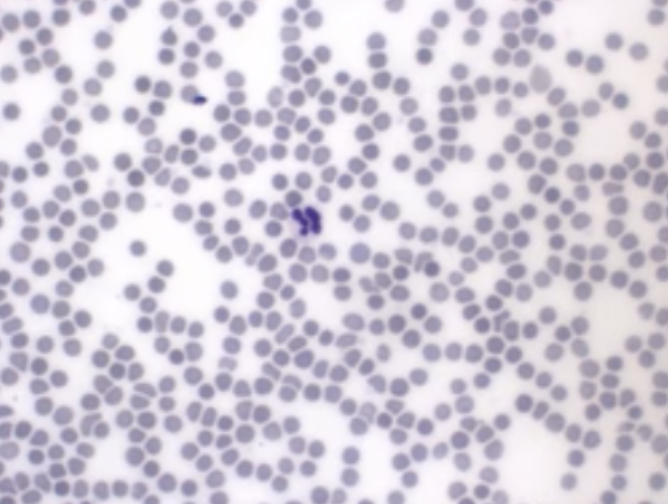

1/67
Name | Mastery | Learn | Test | Matching | Spaced | Call with Kai |
|---|
No analytics yet
Send a link to your students to track their progress

What are the arrows pointing to?
Fibroblasts

What type of cell is highlighted in green?
Neurons

What type of cell is highlighted in yellow?
Glial

What is circled in blue?
Fibers

What type of tissue does this image depict?
Simple squamous epithelial

What tissue type does this image depict?
Simple squamous epithelial

What tissue type does this image depict?
Skeletal muscle

What tissue type does this image depict?
Cardiac muscle

What tissue type does this image depict?
Smooth muscle

What tissue type does this image depict?
Nervous

What tissue type does this image depict?
Simple squamous epithelial

What tissue type does this image depict?
Simple cuboidal epithelium

What tissue type does this image depict?
Simple columnar epithelial

What tissue type does this image depict?
Pseudostratified columnar epithelial

What tissue type does this image depict?
Stratified squamous epithelial

What tissue type does this image depict?
Stratified cuboidal epithelial

What tissue type does this image depict?
Stratified columnar epithelial

What tissue type does this image depict?
Transitional epithelial

What tissue type does this image depict?
Loose areolar connective

What tissue type does this image depict?
Loose adipose connective

What tissue type does this image depict?
Loose reticular connective

What tissue type does this image depict?
Dense irregular connective

What tissue type does this image depict?
Dense regular connective

What tissue type does this image depict?
Hyaline cartilage connective

What tissue type does this image depict?
Elastic cartilage connective

What tissue type does this image depict?
Fibrocartilage connective

What tissue type does this image depict?
Bone connective
What tissue type does this image depict?
Blood connective
What tissue type does this image depict?
Blood connective

What tissue type does this image depict?
Simple cuboidal epithelial

What tissue type does this image depict?
Simple columnar epithelial

What tissue type does this image depict?
Pseudostratified columnar epithelial

What tissue type does this image depict?
Keratinized stratified squamous epithelial

What tissue type does this image depict?
Stratified squamous epithelial

What tissue type does this image depict?
Stratified cuboidal epithelial

What tissue type does this image depict?
Stratified columnar epithelial

What tissue type does this image depict?
Transitional epithelial

Which type of tissue does this image depict?
Hyaline cartilage connective

What tissue type does this image depict?
Loose areolar connective

What tissue type does this image depict?
Loose adipose connective

What tissue type does this image depict?
Loose reticular connective

Which type of tissue does this image depict?
Dense regular connective

Which type of tissue does this image depict?
Dense irregular connective

Which type of tissue does this image depict?
dense elastic connective

Which type of tissue does this image depict?
Hyaline cartilage connective

Which type of tissue does this image depict?
Elastic cartilage connective

Which type of tissue does this image depict?
Fibrocartilage connective

Which type of tissue does this image depict?
Bone connective

Which type of tissue does this image depict?
Skeletal muscle

Which type of tissue does this image depict?
Cardiac muscle

Which type of tissue does this image depict?
Smooth muscle

Which type of tissue does this image depict?
Nervous

What is the orange arrow pointing to?
Ground substance

Which cells have the suffix blast?
Arrow

Which cells have the suffix cyte?
Squares

What type of cell is the arrow pointing to?
Mast cells

What cell is the arrow pointing to?
White blood cells

What cell is the arrow pointing to?
Macrophages

What does the highlighted green part of cartilage represent?
Ground substance

What cells are circled in orange in cartilage?
Chondroblasts

What cells are circled in yellow in cartilage?
Chondrocytes

What part of the cartilage has a orange bar?
Perichondrium

What part of bone are the dark blue arrows pointing to?
Osteoblasts

What part of bone are the light blue arrows pointing to?
Osteoclasts

What type of bone tissue does the picture depict?
Compact

What type of bone tissue does the picture depict?
Spongey

What are the blue arrows of compact bone pointing to?
Osteocytes

What are the red arrows of spongey bone pointing to?
Trabeculae